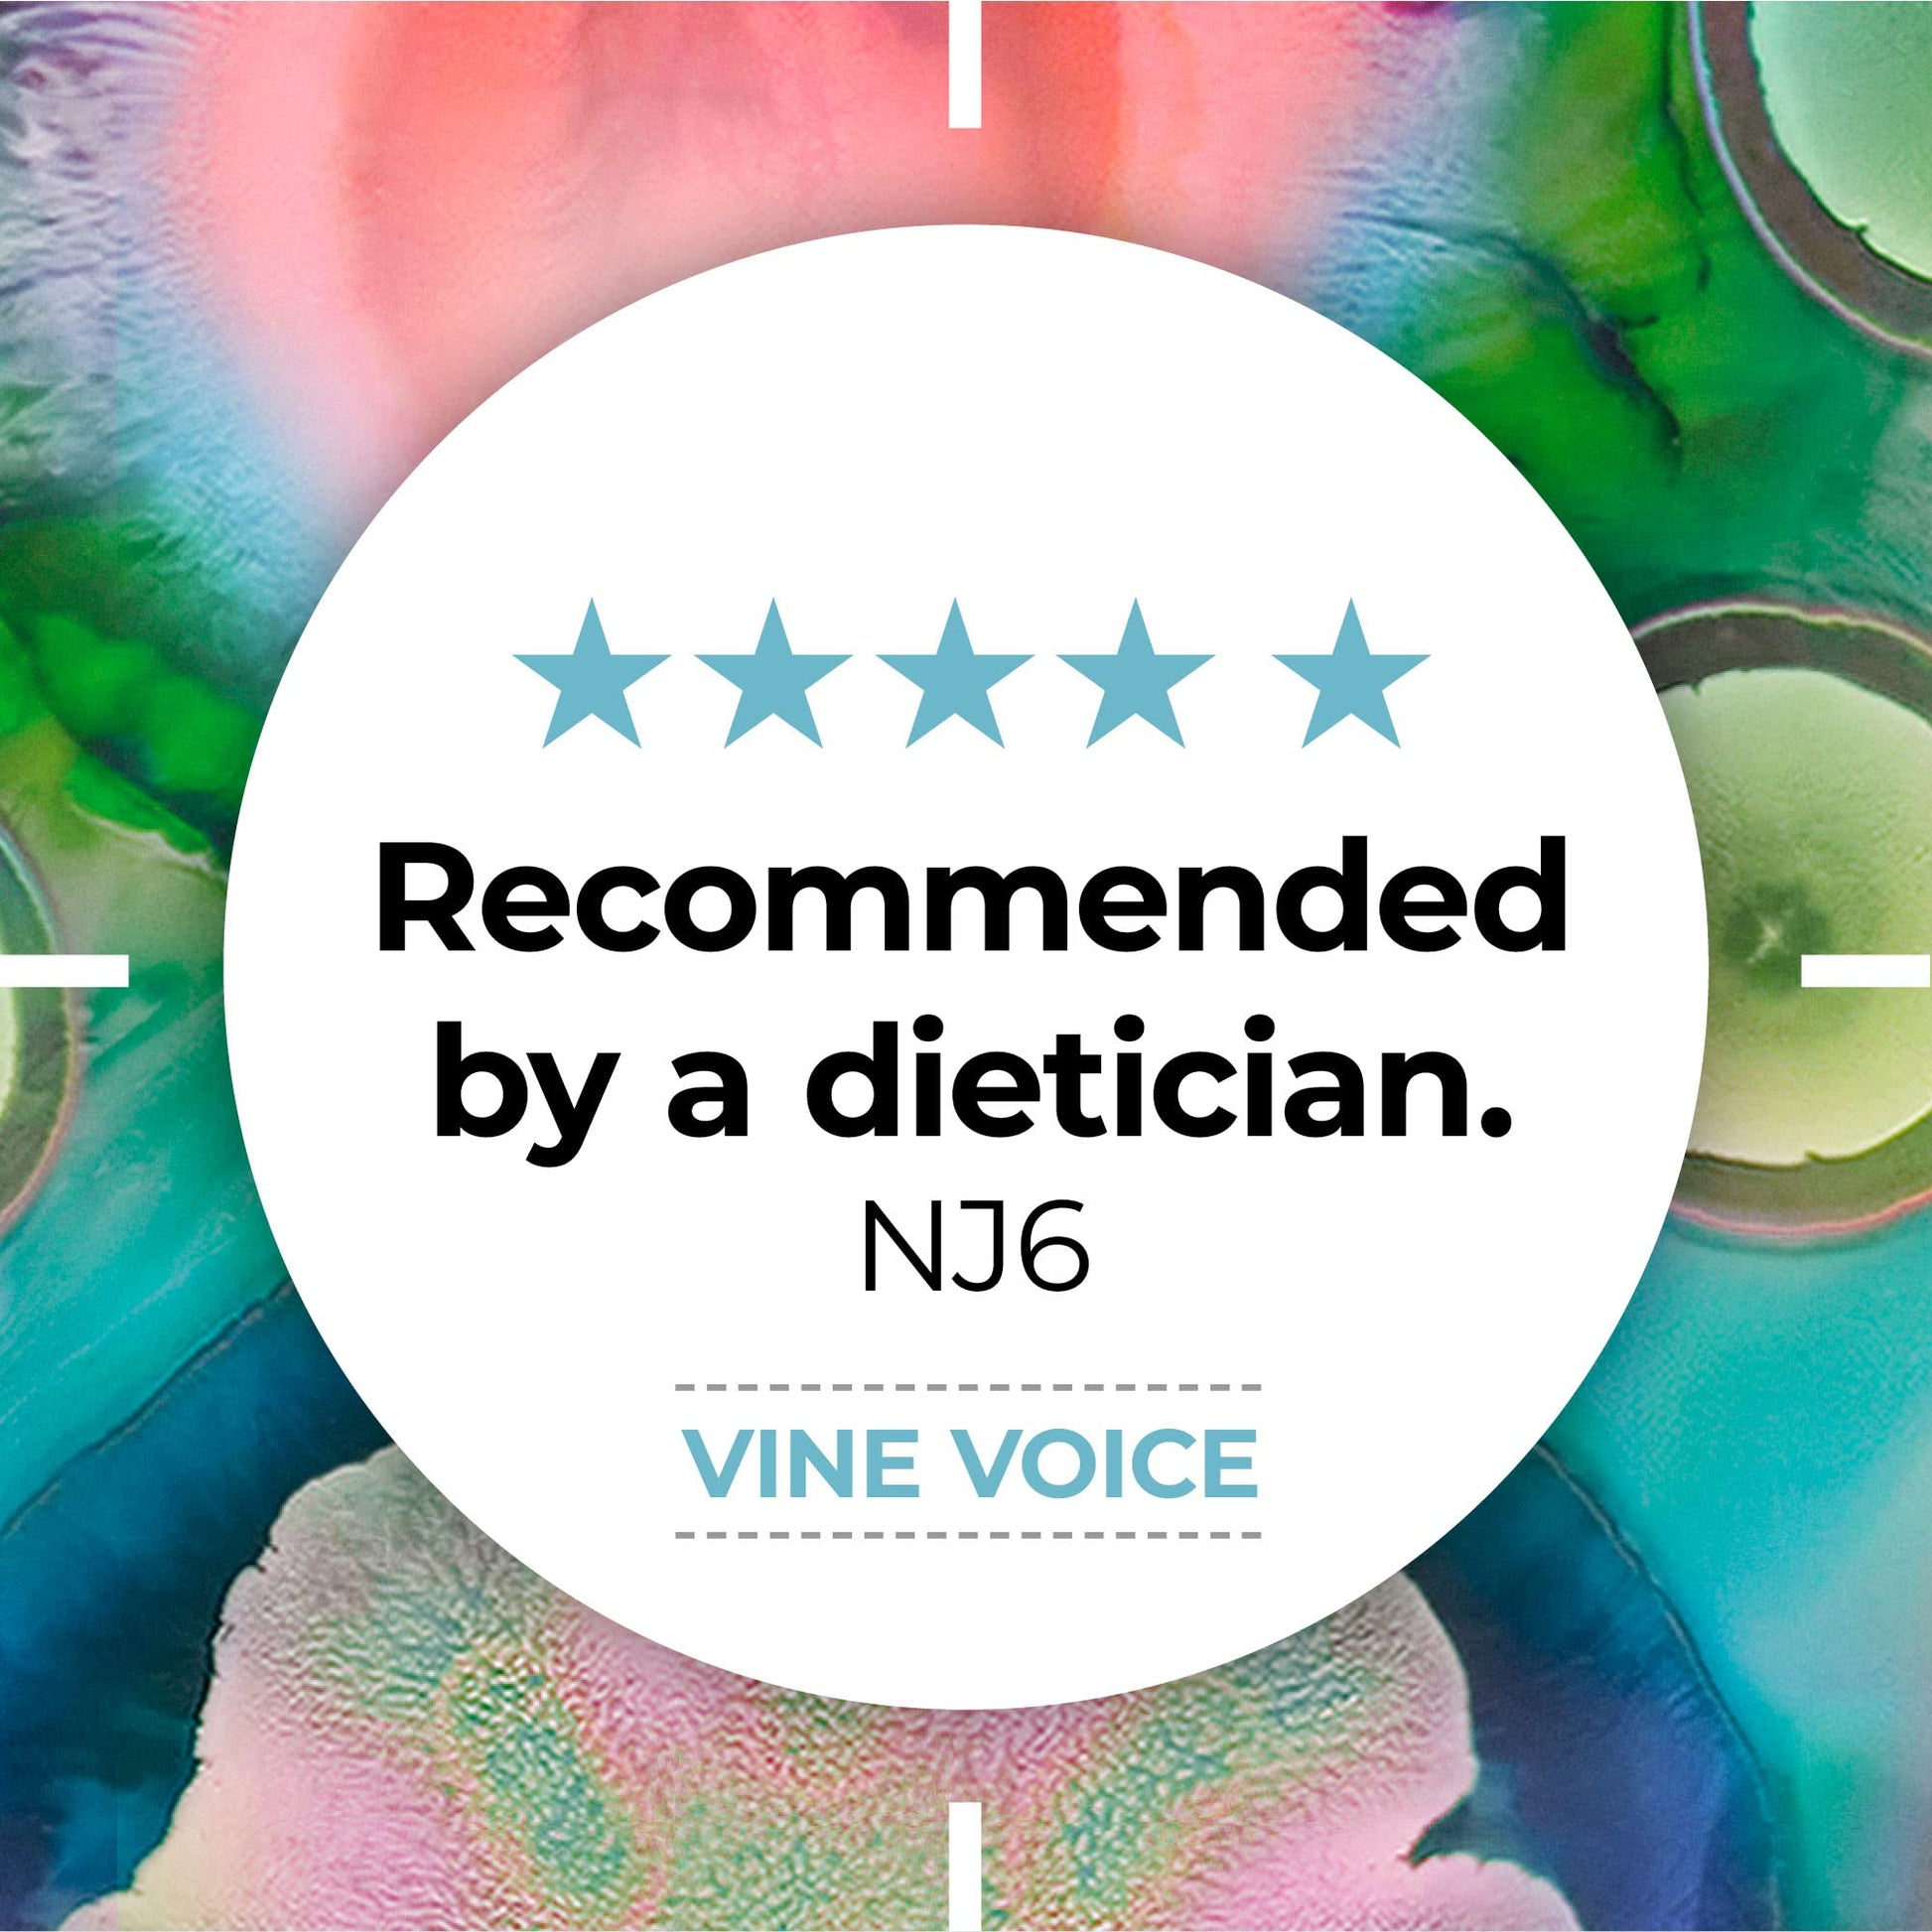

Alflorex Plus Calcium – Daily Gut Health Probiotics - Contains Calcium & Bifidobacterium Longum Bacterial Culture Strain 35624 – No Refrigeration Required - 30 Capsules
Alflorex Plus Calcium – Daily Gut Health Probiotics - Contains Calcium & Bifidobacterium Longum Bacterial Culture Strain 35624 – No Refrigeration Required - 30 Capsules
Couldn't load pickup availability
- Free 30 days returns
- 100% Satisfaction Guarantee
Shipping & Delivery
Shipping & Delivery
At GNMart, we understand that receiving your order in a timely and efficient manner is important to you. That's why we offer fast and reliable shipping options to ensure that your products arrive as quickly as possible.
Shipping Summary:
- Packages are shipped from Monday to Friday.
- The usual time for processing an order is 1 to 3 business days, but may vary depending on the availability of products ordered. This period excludes delivery times, which depend on your geographic location.
- We provide tracking for every order. Tracking will be available once your product is shipped. Each individual product may be shipped from different fulfillment centers across the globe as our product research team spends the time to source quality yet affordable products.
Estimated delivery times:
- Standard Shipping: 3-7 business days
- Expedited Shipping: 2-5 business days
- International Shipping: 10 - 15 business days
Please note that these are estimates, not guarantees. Delivery time depends on a number of variables, and there may be delays such as bad weather affecting air transport, or a package being held for inspection by Customs. GNMart.com is not liable for any delays in international transportation or customs clearance.
Shipping Status:
As soon as your order ships, you'll receive a shipping confirmation email that includes your tracking number.
If you don't receive a shipping confirmation email right away, don't worry! We know the delivery date or date range provided at checkout and we'll be sure to deliver the items within that timeframe.
Order changes:
Please contact our customer support if the order needs to be canceled or modified.
Item not received:
If you've successfully placed an order and haven't received it yet while the tracking status shows it's delivered. you'd wish to contact the carrier to hunt out your Cover as once the item is Covered we have control over it (once it’s by the carrier), but if still persists kindly email us
Damaged Parcel
If your package has been delivered in a PO Box, please note that we are not responsible for any damage that may result (consequences of extreme temperatures, theft, etc.).
If you have any questions regarding shipping or want to know about the status of an order, please contact us or email to info@gnmart.com.
Returns & refunds
Returns & refunds
You may return most items within 30 days of delivery for a full refund.
To be eligible for a return, your item must be unused and in the same condition that you received it. It must also be in the original packaging.
Several types of goods are exempt from being returned. Perishable goods such as food, flowers, newspapers or magazines cannot be returned. We also do not accept products that are intimate or sanitary goods, hazardous materials, or flammable liquids or gases.
To complete your return, we require a tracking number, which shows the items which you already returned to us.
There are certain situations where only partial refunds are granted (if applicable)
- Any item not in its original condition, is damaged or missing parts for reasons not due to our error
- Any item that is returned more than 30 days after delivery
Items returned to us as a result of our error will receive a full refund.
You should expect to receive your refund within four weeks of giving your package to the return shipper, however, in many cases you will receive a refund more quickly. This time period includes the transit time for us to receive your return from the shipper (5 to 10 business days), the time it takes us to process your return once we receive it (3 to 5 business days), and the time it takes your bank to process our refund request (5 to 10 business days).
If you need to return an item, please contact us with your order number and details about the product you would like to return. We will respond quickly with instructions for how to return items from your order.
Shipping Cost
We'll pay the return shipping costs if the return is a result of our error (you received an incorrect or defective item, etc.). In other cases, you will be responsible for paying for your own shipping costs for returning your item. Shipping costs are non-refundable. If you receive a refund, the cost of return shipping will be deducted from your refund.
Depending on where you live, the time it may take for your exchanged product to reach you, may vary.
If you are shipping an item over $75, you should consider using a trackable shipping service or purchasing shipping insurance. We don’t guarantee that we will receive your returned item.
Refund:
- Purchases may be returned within 30 days of the shipping date for a refund.
- Refund will be issued to your original form of payment.
Claims:
Claims related to the product. Be sure to check the details of your purchase carefully before you make the payment, and check the contents of the package(s) promptly upon receipt. If you have a problem with the product, visit our Support Center to find out about return shipping arrangements.
WHICH CIRCUMSTANCES WE OFFER RETURND & REFUND:
WRONG PRODUCT:
If you discover your order is flawed please contact us Mail: info@gnmart.com. With photos of the wrong product we will providing a return shipping label. Once it is tracking we will ship a replacement a product immediately.
Damages and issues
Please inspect your order upon reception and contact us immediately if the item is defective, damaged or if you receive the wrong item, so that we can evaluate the issue and make it right.
Exceptions / non-returnable items
Certain types of items cannot be returned, like perishable goods (such as food, flowers, or plants), custom products (such as special orders or personalized items), and personal care goods (such as beauty products). We also do not accept returns for hazardous materials, flammable liquids, or gases. Please get in touch if you have questions or concerns about your specific item. Unfortunately, we cannot accept returns on sale items or gift cards.
Exchanges
The fastest way to ensure you get what you want is to return the item you have, and once the return is accepted, make a separate purchase for the new item.







Alflorex Plus Calcium – Daily Gut Health Probiotics - Contains Calcium & Bifidobacterium Longum Bacterial Culture Strain 35624 – No Refrigeration Required - 30 Capsules
More Details
Gut health made simple with Alflorex Plus Calcium. Each capsule contains calcium which contributes to the normal function of digestive enzymes and 10^9 of the live friendly bacteria – strain 35624 – from the Bifidobacterium longum family. Start your journey today. The bacteria may be considered a probiotic; however, the use of this term is not permissible in commercial communications under European food law.More Info
- Manufacture: Novozymes A/S
- Brand: PrecisionBiotics
- Size: 30 Count (Pack of 1)
Recently viewed products
-
Recently viewed products